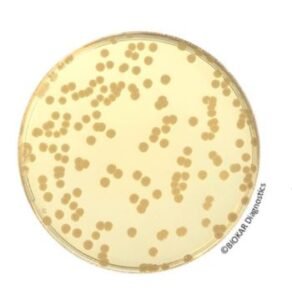
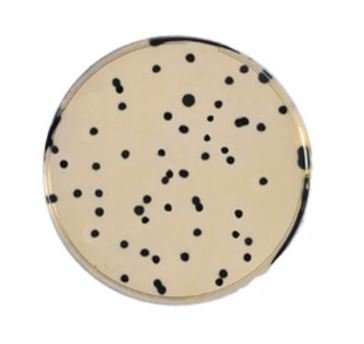
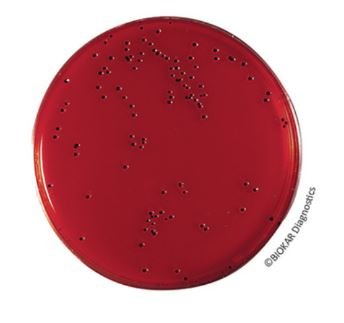
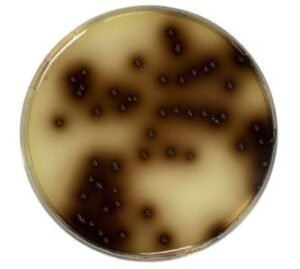
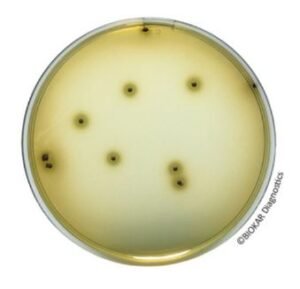
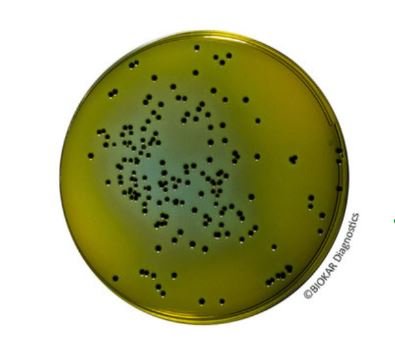

Description
Trypto Casein-Soy Agar is a universal nutrient medium suitable for a wide range of uses. In light of its excellent nutritive value, it can be used for the growth and isolation of both aerobic and anaerobic bacteria and to favor the development of the most fastidious microorganisms. Poured in plates or on strips, it is useful in rapid tests for examining the contamination of surfaces. In addition, under the denomination TSA (Tryptic Soy Agar), this formula corresponds to the reference medium used for the evaluation of productivity and selectivity criteria in the context of the ISO 11133 standard.